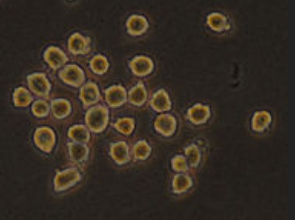

Cloning ethics - quiz
This is a simple activity to give students a little more insight into some of the ways in which we make ethical decisions.
It links to ToK but it also helps students to understand the views of others during a debate.
How do we make difficult decisions when there seems to be both good and bad aspects to the situation?
The types of decision making illustrated in the quiz help us to understand ourselves a little better but also, most importantly, how other people may quite legitimately hold views different to our own.
This short quiz will help you identify how you make such decisions. 
You might not agree entirely with any one answer but choose the answer which you like the best in each question.
Concentrate mostly on the reasons why.
Answer each of the questions in turn.
1. Is it OK to cut a strawberry plant into many pieces and grow each one as a clone of the parent plant?
There are no wrong answers. Move on to the next question.
2. Is it OK to produce clones of human cancer cells in the lab so that new drugs can be tested on them? The cells will never leave the lab.
Well done keep going.
3. Is it OK to produce clones of human stem cells from an umbilical cord to carry out experiments on tissue culture, to grow human organs?
Great! Carry on.
4. Is it OK to produce clones of pigs using lab techniques so that farmers can produce more food to feed an ever growing population?
Well done. Just one more question.
5. Is it OK to produce clones of human immune cells in the lab so that
antibodies can be harvested to make testing kits?
How did you answer?
These explanations are really only simple outlines of these ideas. The aim is to help you understand why other people ma have different views. If Ethics is something you'd like to know more about, ask your TOK teacher.
Mostly A
You seem to be using Kant’s Categorical Imperative. This work by imagining if everyone did this. For something to be ethically correct it must be ok for everyone to do it.
Mostly B
You seem to favor "Situation ethics" This approach looks at the reason for the clone to be made and decides whether it is for selflessness reasons or not. Situation ethics would say cloning is not acceptable is if someone were to create the clone for selfish reasons.
Mostly C
You seem to be using an approach called Utilitarianism. If the cloning caused more overall happiness than it caused suffering, then it is OK. Many people would also ask whether it is right to cause any amount of the suffering even if many people benefit. For example it would be wrong to kill a baby even if it cured a hundred hospital patients.
Mostly D
You have chosen answers which follow Natural Law. This states that something is ethical if it occurs naturally. So since cloning skin cells is a non-natural process it goes against Natural Law. But, cloning strawberries, that happens naturally OK.
IB Docs (2) Team